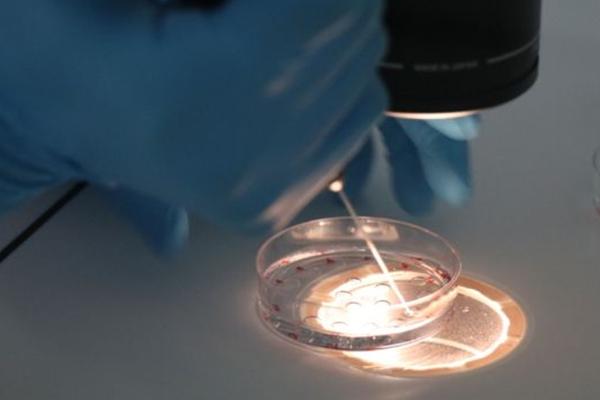
2023格鲁吉亚自己辅助生殖费用预估，是否需要一次付清还得看个人选择

时间:2023-10-26 分类: 试管资讯 查看: 41
2023格鲁吉亚自己辅助生殖费用预估,是否需要一次付清还得看个人选择,截止到目前,选择去海外做试管的家庭越来越多,其中格鲁吉亚试管技术因费用低、成功率高,吸引了很多不孕不育患者前往,可能有些患者对格鲁吉亚做试管的助孕费用还不是很了解,下面我们就来详细说明下。
试管婴儿实质上就是"助孕怀孕"和"胚胎移植"。简单来说就是从卵巢中取出了成熟卵细胞,在助孕与三代试管生子共同培养完成怀孕,怀孕卵于试管内发育成胚胎,等胚胎进一步发育到囊胚期时,将囊胚移入民主的自己体内,在自己体内继续发育直到瓜熟蒂落,这就是试管婴儿的整个过程。而“自己辅助生殖”的基本流程与我们通常所说的“试管婴儿”并没有什么太大的区别,仅有的区别就是将所培养的胚胎选择移植回母亲自己体内还是植入第三者体内,如果植入第三者体内则称为"自己辅助生殖"。
1、夫妻胚胎自己辅助生殖
2、丈夫三代试管生子+助孕自己辅助生殖
3、助孕+助孕自己辅助生殖
相比做试管婴儿自己辅助生殖产生的费用是非常高的,所以大家在自身情况允许的条件下,尽量不要选择自己辅助生殖,以免给家庭造成太大的经济负担。
一般而言在做自己辅助生殖的时候都需要在自己辅助生殖方案确定之后就签订合同和交付费用,这样才能保障自己辅助生殖的开展,具体的费用交付细节大家也可以直接咨询相关医院和医生,如果是和医院沟通的,一定要注意医院医院的正规性,以免上当受骗。具体费用如下:
和做试管婴儿一样,自己辅助生殖也不是一次就能成功的,而且选择的自己辅助生殖对象也非常关键,所以每个人自己辅助生殖产生的费用都不会不一样,一般只要大家选择了专业正规的自己辅助生殖机构,所产生的费用都是比较合理的。
小提示:关于“2023格鲁吉亚自己辅助生殖费用预估,是否需要一次付清还得看个人选择”的内容就介绍到这里了,总的来说,当前在格鲁吉亚通过自己助孕的费用还是比较昂贵的,因此大家也要做好心理准备。此外,大家在选择自己助孕的时候,一定要提前进行咨询,并讨论好后续的相关事项,以免引发不必要的麻烦。